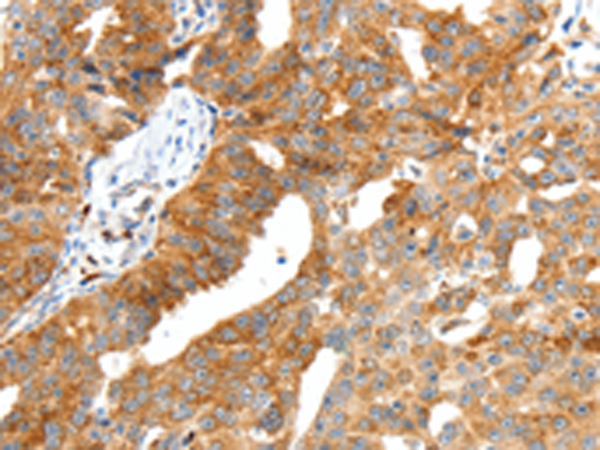

别名:应用:IHC
反应种属:Human, Mouse, Rat
规格:50μl/100μl
| Description |
|---|
| Secretin belongs to the glucagon family. This protein is an endocrine hormone and its major site of production is the endocrine S cells located in the proximal small intestinal mucosa. The release of active secretin is stimulated by either fatty acids or an acidic pH in the duodenum. This hormone stimulates the secretion of bicarbonate-rich pancreatic fluids and has also been shown to regulate the growth and development of the stomach, small intestine, and pancreas. Secretin deficiency has been implicated in autistic syndrome, suggesting that the hormone could have a neuroendocrine function in addition to its role in digestion. |
| Specification | |
|---|---|
| Swissprot | P09683 |
| Host/Isotype | Rabbit IgG |
| Storage | Store at 4°C short term. Aliquot and store at -20°C long term. Avoid freeze/thaw cycles. |
| Species Reactivity | Human, Mouse, Rat |
| Immunogen | Synthetic peptide of human SCT |
| Formulation | pH7.4 PBS, 0.05% NaN3, 40% Glycerol |
| Application | |
|---|---|
| IHC | 1/50-1/200 |
| ELISA | 1/2000-1/5000 |
![]() |
The image is immunohistochemistry of paraffin-embedded Human thyroid cancer tissue using P04447(SCT Antibody) at dilution 1/40. (Original magnification: ×200) |
![]() |
The image is immunohistochemistry of paraffin-embedded Human ovarian cancer tissue using P04447(SCT Antibody) at dilution 1/40. (Original magnification: ×200) |
本公司的所有产品仅用于科学研究或者工业应用等非医疗目的,不可用于人类或动物的临床诊断或治疗,非药用,非食用。
暂无评论
本公司的所有产品仅用于科学研究或者工业应用等非医疗目的,不可用于人类或动物的临床诊断或治疗,非药用,非食用。
中文

发表回复